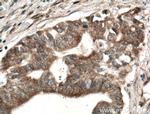
PSAT1 Antibody in Immunohistochemistry (Paraffin) (IHC (P))
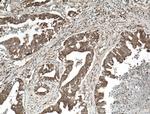
PSAT1 Antibody in Immunohistochemistry (Paraffin) (IHC (P))

Search
Proteintech
PSAT1 Polyclonal Antibody
{{$productOrderCtrl.translations['antibody.pdp.commerceCard.promotion.promotions']}}
{{$productOrderCtrl.translations['antibody.pdp.commerceCard.promotion.viewpromo']}}
{{$productOrderCtrl.translations['antibody.pdp.commerceCard.promotion.promocode']}}: {{promo.promoCode}} {{promo.promoTitle}} {{promo.promoDescription}}. {{$productOrderCtrl.translations['antibody.pdp.commerceCard.promotion.learnmore']}}
产品信息
10501-1-AP
种属反应
已发表种属
宿主/亚型
分类
类型
抗原
偶联物
形式
浓度
规格
纯化类型
保存液
内含物
保存条件
运输条件
产品详细信息
Immunogen sequence: MDAPRQVVN FGPGPAKLPH SVLLEIQKEL LDYKGVGISV LEMSHRSSDF AKIINNTENL VRELLAVPDN YKVIFLQGGG CGQFSAVPLN LIGLKAGRCA DYVVTGAWSA KAAEEAKKFG TINIVHPKLG SYTKIPDPST WNLNPDASYV YYCANETVHG VEFDFIPDVK GAVLVCDMSS NFLSKPVDVS KFGVIFAGAQ KNVGSAGVTV VIVRDDLLGF ALRECPSVLE YKVQAGNSSL YNTPPCFSIY VMGLVLEWIK NNGGAAAMEK LSSIKSQTIY EIIDNSQGFY VCPVEPQNRS KMNIPFRIGN AKGDDALEKR FLDKALELNM LSLKGHRSVG GIRASLYNAV TIEDVQKLAA FMKKFLEMHQ L (1-370 aa encoded by BC004863)
靶标信息
The protein encoded by this gene is likely a phosphoserine aminotransferase, based on similarity to proteins in mouse, rabbit, and Drosophila. Alternative splicing of this gene results in two transcript variants encoding different isoforms.
仅用于科研。不用于诊断过程。未经明确授权不得转售。
生物信息学
蛋白别名: endometrial progesterone-induced protein; Phosphohydroxythreonine aminotransferase; Phosphoserine aminotransferase; phosphoserine transaminase; PSAT; unnamed protein product
基因别名: EPIP; NLS2; PSA; Psa1; PSAT; PSAT1; PSATD
UniProt ID: (Human) Q9Y617
Entrez Gene ID: (Human) 29968, (Rat) 293820